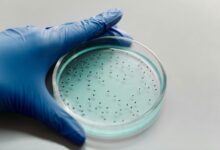
scientific keyword discovery hub context

Revolutionizing Instagram Viewing with Picnob: The Ultimate Web-Based Tool and Anonymous Story Viewer”
Introduction
In today’s digital age, Instagram has emerged as one of the most popular social media platforms, especially when it comes to sharing short videos like reels and engaging stories. However, there are times when you want to view and download Instagram content anonymously, without leaving a trace. Enter Picnob, the web-based tool that’s changing the game for Instagram enthusiasts.
What is Picnob?
Picnob is a powerful web-based tool and anonymous Instagram story viewer that’s making waves in the social media landscape. With Picnob, users can seamlessly view and download Instagram reels and stories without compromising their privacy. This innovative tool empowers Instagram users to enjoy their favorite content discreetly and conveniently.
Key Features of Picnob
- Anonymous Viewing: One of the standout features of Picnob is its ability to let users view Instagram content anonymously. You can explore Instagram stories and reels without worrying about leaving any footprints or notifications.
- User-Friendly Interface: Picnob boasts a user-friendly interface that is easy to navigate, even for those who may not be tech-savvy. You can get started within seconds, making it accessible to users of all skill levels.
- No Downloads Required: Unlike some other Instagram viewer tools, Picnob operates entirely online, eliminating the need for any downloads or installations. This ensures that your device remains clutter-free and secure.
- High-Quality Downloads: Picnob enables users to download Instagram reels and stories in high-quality, preserving the content’s integrity and visual appeal.
- Compatibility: Picnob works seamlessly across various devices, including smartphones, tablets, and desktop computers. You can access it from anywhere with an internet connection.
How to Use Picnob
Using Picnob is a breeze. Here’s a step-by-step guide to get you started:
- Open your web browser and visit the Picnob website.
- Enter the username or link of the Instagram account whose content you want to view anonymously.
- Browse through the available stories and reels and click on the ones you’d like to view or download.
- Enjoy anonymous viewing, and if you wish to download, simply click the download button provided.
- Your downloaded content will be saved on your device for offline viewing.
Why Choose Picnob?
Picnob stands out in the realm of Instagram viewers for several compelling reasons:
- Privacy: Your identity remains concealed while you explore Instagram content, ensuring a discreet and confidential experience.
- Ease of Use: Picnob’s intuitive interface ensures that anyone, regardless of their technical proficiency, can navigate and utilize the tool effectively.
- No Installation: There’s no need to clutter your device with additional apps or software. Picnob operates online, streamlining your user experience.
- High-Quality Content: Enjoy Instagram reels and stories in the best possible quality, preserving the visual appeal of the content you love.
- Universal Access: Picnob is accessible from any device with an internet connection, giving you the freedom to use it whenever and wherever you like.
Conclusion
In a world where online privacy and user experience are paramount, Picnob emerges as a game-changer for Instagram enthusiasts. With its anonymous viewing capabilities, user-friendly interface, and high-quality content downloads, Picnob revolutionizes how users interact with Instagram stories and reels. Say goodbye to the limitations of traditional Instagram viewing and embrace the future with Picnob. Try it today and elevate your Instagram experience to a whole new level.